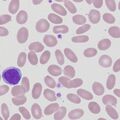
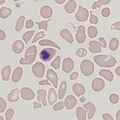
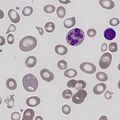
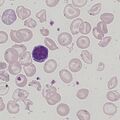
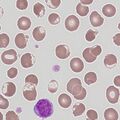
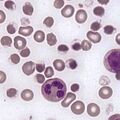
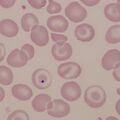
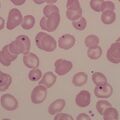
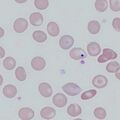

Uncategorised files
Showing below up to 50 results in range #101 to #150.
- Ec6.jpg 472 × 472; 45 KB
- Ellip0.png 472 × 472; 59 KB
- Ellip1.png 472 × 472; 75 KB
- Ellip1A.png 472 × 472; 132 KB
- Ellip2.jpg 449 × 445; 26 KB
- Ellip3.jpg 472 × 472; 50 KB
- Ellip4.JPG 472 × 472; 58 KB
- Ellip4.jpg 472 × 472; 58 KB
- Ellip5.jpg 472 × 472; 59 KB
- Ellip6.jpg 472 × 472; 59 KB
- ExFl1.jpg 472 × 472; 64 KB
- ExFl2.jpg 472 × 472; 46 KB
- ExFl3.jpg 472 × 472; 60 KB
- ExFl4.jpg 472 × 472; 43 KB
- FL.jpg 315 × 315; 37 KB
- FVETc.jpg 472 × 472; 67 KB
- Fr0.png 472 × 472; 83 KB
- Fr1.png 472 × 472; 68 KB
- Fr2.jpg 472 × 472; 39 KB
- Fr3.png 472 × 472; 57 KB
- Fr4.jpg 472 × 472; 43 KB
- Fr5.jpg 472 × 472; 78 KB
- Fr6.jpg 472 × 472; 79 KB
- Fr7.jpg 472 × 472; 99 KB
- Fr8.jpg 472 × 472; 89 KB
- Gallery.jpg 472 × 472; 37 KB
- Gallery new.jpg 472 × 472; 39 KB
- Gallery new 2.jpg 472 × 472; 48 KB
- Gallery newer.jpg 472 × 472; 40 KB
- Getting fixed.jpg 756 × 720; 94 KB
- HCL.jpg 315 × 315; 34 KB
- HG0A.png 472 × 472; 47 KB
- HG1.png 472 × 472; 58 KB
- HG1A.png 472 × 472; 79 KB
- HG2.jpg 472 × 472; 68 KB
- HG3.jpg 472 × 472; 62 KB
- HG4.jpg 472 × 472; 115 KB
- HG5.jpg 591 × 591; 111 KB
- HJ0.png 472 × 472; 68 KB
- HJ1.png 472 × 472; 87 KB
- HJ1A.png 472 × 472; 115 KB
- HJ2.jpg 472 × 472; 32 KB
- HJ2A.jpg 472 × 472; 35 KB
- HJ3.jpg 472 × 472; 58 KB
- HJ4.jpg 472 × 472; 67 KB
- HJ5.jpg 472 × 472; 49 KB
- HypoC0.png 596 × 639; 166 KB
- HypoC0a.png 472 × 472; 98 KB
- HypoC1.png 472 × 472; 158 KB
- HypoC2.jpg 472 × 472; 32 KB